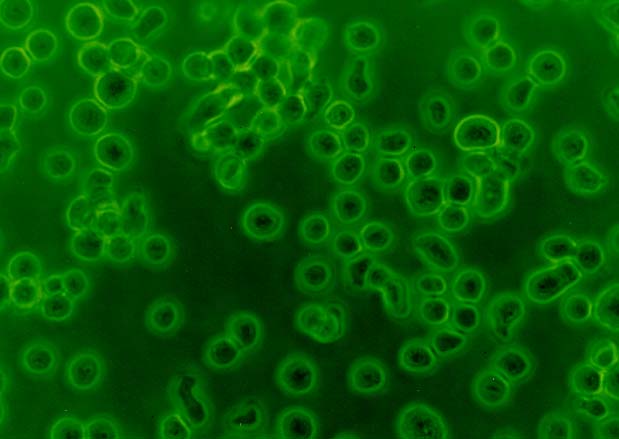

|
ハイブリドーマとは
生体内において抗体を産生している細胞はBリンパ球です。抗体を、大量にかつ効率的に生産するには、Bリンパ球を培養しなければなりません。しかし、通常、生体内にあるBリンパ球を生体外で長期的に培養することはできません。そこで、生体外でも無限に増殖するガン細胞とBリンパ球を細胞融合して、生体外で培養もでき、抗体も産生できる細胞、すなわちハイブリドーマを作成することが考え出されました。ハイブリドーマは抗体を産生し、なおかつ生体外において無限に増殖することができます。一個のハイブリドーマ細胞が細胞分裂を繰り返してできた細胞集団は均質な抗体を産生します。これをモノクローナル抗体といい、この均質性のことをクローンと呼びます。写真はヒト型ハイブリドーマHB4C5細胞で、ヒト肺ガン特異的モノクローナル抗体を産生する細胞です。丸い一粒一粒が一個の細胞です。一個 の細胞の直径は、およそ20ミクロンです。
|
ハイブリドーマHB4C5細胞の顕微鏡写真